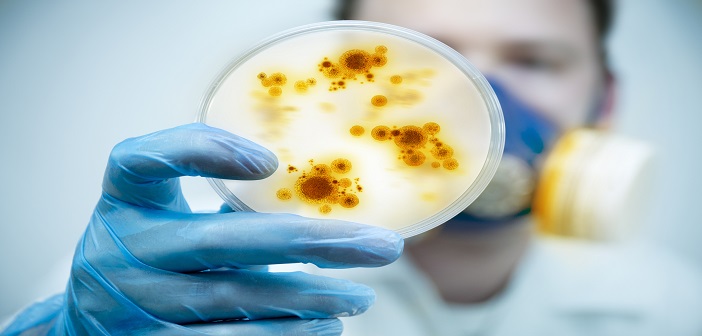
diskusi-seputar-intelijen---part-1

link has been copied

Agan ini masih malu-malu nyeritain tentang dirinya.
Koneksi
Membalas post sibuk.nyaleg Ada baiknya sbg pembelajaran jg.. Mending sekarang mulai sweeping aja yg ga punya kewarganegaraan (paspor ato ktp) kita usir. Tuh ada sekitar 3000an di meikarta tanpa visa kerja Mo coba dari yg deket dulu aja :lehuga
Jokowi Pakai Istilah "ISIS Eks WNI", Ini Penjelasan Istana
Thread dihapus
Membalas thread Gabener.edan2 Hadeh.... https://scontent-hkg3-2.xx.fbcdn.net/v/t1.0-9/37054986_635608270150409_3204228177580785664_n.jpg?_nc_cat=110&efg=eyJpIjoiYiJ9&_nc_ohc=Axh5WriIHfAAX-8tCzO&_nc_ht=scontent-hkg3-2.xx&oh=44e928c0c4002c9210f9fd2c5fecddc4&oe=5ECB3733
Seperti Inilah Indonesia Jika Ahok Jadi Presiden
Thread dihapus
Membalas post inovator.4id cak nun itu mirip 1 mario teguh, 2 tony blank, 3 pak ndul, omonganya muter muter ga jelas Budayawan kuwi bebas, mo ukiranya dibuat mlungker atau lurus ya sah sah saja Wajar klo ente ga mudeng,itu melambangkan seberapa besar jiwa seni ente :lehuga
Ainun Najib: Menteri Mahpud Madura Sebodoh bodohnya Orang bodoh
Thread dihapus
Membalas thread F1reFlies TS lagi giring opini dimana yang gasetuju si prof ketua bpip itu islam garis keras Pic dari CNNINDONESIA dirubah dengan pic pic organisasi terlarang dan pks agar onani otak dapat dukungan :lehuga Ga lupa link web jadi Khilafah islamiyah biar makin keren :lehuga
Sebut Agama Halangi Pancasila, Bubarkan BPIP Menggema
Membalas post arulrasyid ga akan keluar stetmen kyk gt kalau ga ada tingkah2 aneh dr org2 berjubah agama mereka yg berjubah agama hrsnya jadi panutan skrg bgmna mana mau jdi panutan kalau di dengar sja tentang mrk sdh menyeramkan apalagi dilihat dan diikuti Diera perang asimetris seperti sekarang jangan terjebak pada jub...
PA 212: Kepala BPIP Musuh Pancasila Sesungguhnya
Membalas thread F1reFlies Akibat kelamaan kuliah di Harvard Univetsity uteknya jadi western minded,pancasila mo diisi nilai nilai ala barat kali yah :D Tapi itu PA 212 apasih ikut ikutan,dasar ga jelas. Lebih baik ngikut bisnis dan pemberdayaan ekonomi umat kek syafii antonio itu kan bagus. Jelas kerjanya jelas hasilnya
PA 212: Kepala BPIP Musuh Pancasila Sesungguhnya
Membalas post kadalgurun19 waktu penggorengan ..... ketika ada yang ngomong : kitab suci = fiksi, adem ayem aja ? tanya kenafa ? :bingungs Kitab suci itu fiksi ala Rocky Gerung mah da ada effectnya karena dia ga punya posisi apa apa di pemerintahan jadi cuman sekedar bacot Tapi ketika seorang kepala bpip berucap Pancasil
Video Ungkapan pahit Kepala BPIP - AGAMA MUSUH TERBESAR PANCASILA - Benarkah ?
Membalas thread muhammadeltar Ga aneh karena yg berkuasa sekarang adalah pdip,dari pemikiran kader kader pdip seperti trimedia panjaitn yang bercita cita ngehapus syariat,dari cita cita eva sunsaya yang ngomong mo nginteli masjid,itu belum musdah mulai yang dekat dengan mbok Mega dll Jadi klo pemikiran sumir dan banyak muncul u
Video Ungkapan pahit Kepala BPIP - AGAMA MUSUH TERBESAR PANCASILA - Benarkah ?
Membalas post emiliaw Si ace ini adalah bukti banyak orang yg bisa membaca tapi tidak mengerti apa yg dia baca :wakaka Atau jangan2 dia cuma baca judul langsung komen :lehuga Si Ace itu S3 tong,dia tidak sebaik seperti yang ente bayangin Btw pemikiran si prof mengenai minoritas adalah terhubung dengan sekularitas ind...
Kepala BPIP Sebut Agama Musuh Terbesar Pancasila, Golkar: Pikiran Sesat
Membalas post fat_279 Hati hati bicara otoritas tertinggi,secara salah salah malah alasan ente sebagai justifikasi untuk pecinta khilafah untuk membangun kekhilafahan dibawah seorang kholifah Arab bukan otoritas tertinggi dunia islam,walau islam tak bisa dipisahkan dengan arab secara historis,arab di pandang penting ka
Kepala BPIP Sebut Agama Jadi Musuh Terbesar Pancasila
Membalas post handratas Maaf tp ane simpulkan kalau ente TS yg ga ngerti sama berita yg dibawa... apa ente juga ga setuju dengan pancasila? Pertanyaan yg kenak kanakan :capedes Bedakan antara agama dengan pergerakan berbaju agama yang bertujuan kekuasaan. Masa ente ga bisa bedain Klo agama adalah musuh terbesar pan
Kepala BPIP Sebut Agama Jadi Musuh Terbesar Pancasila
Membalas post ajacid kalo bacanya dengan PIKIRAN TERBUKA sih...!!! SEMUA KEFANATIKAN SEMUA AGAMA jadi musuh NKRI...!!! . . hanya saja...contoh yg di bawa prof ini...AGAMA KADRUN...!!! Contoh generalisir...Agama kadrun apa sih ? ISLAM Agama si prof? ISLAM Apakah dia kadrun juga :lehuga
Kepala BPIP Sebut Agama Jadi Musuh Terbesar Pancasila
Copyright © 2026, Kaskus Networks, PT Darta Media Indonesia